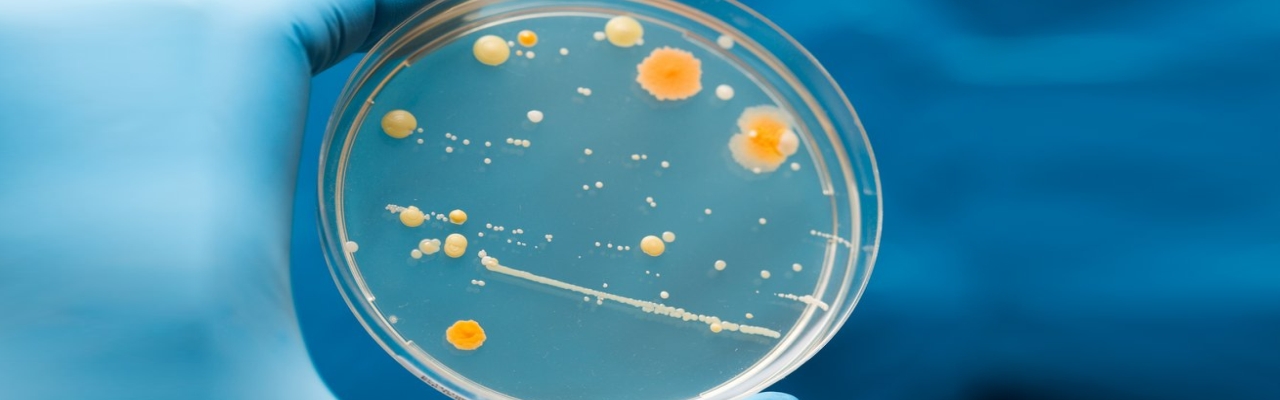
NUTRIENT-M

RECENTLY VIEWED PRODUCTS
NUTRIENT-M
NUTRIENT-M, our advanced microbial culture activator meticulously crafted to optimize agricultural productivity and soil health. Formulated with a potent blend of beneficial microbes, NUTRIENT-M enhances nutrient availability in the soil, promoting robust plant growth and higher yields. Suitable for diverse crops and soil types, this eco-friendly solution supports sustainable farming practices by reducing reliance on synthetic fertilizers. Easy to apply and available in various sizes, NUTRIENT-M ensures cost-effective and efficient soil enhancement for both small-scale and large-scale agricultural operations. Elevate your farming endeavors with NUTRIENT-M from our trusted specialty chemicals manufacturer, where innovation meets excellence in agricultural solutions.

PRODUCT FEATURES :
- Microbial Diversity: Contains a diverse mix of beneficial microbes that enhance soil health and fertility.
- Nutrient Cycling: Facilitates the breakdown of organic matter, releasing nutrients essential for plant growth.
- Versatile Application: Ideal for use in crops, orchards, vineyards, and turf management.
- Environmental Benefits: Promotes soil structure improvement and reduces nutrient runoff, supporting eco-friendly farming practices.
STANDARD PACK SIZES
- 1 ltr Carboy
RECENTLY VIEWED PRODUCTS